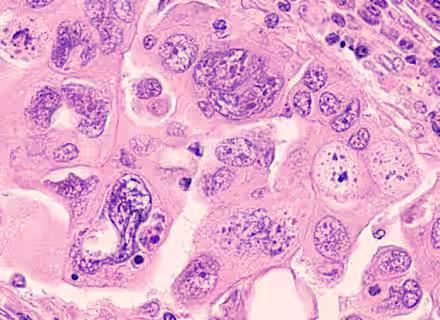
A microscopic image of a tissue sample stained with hematoxylin and eosin, showing clusters of irregularly shaped cells with prominent nuclei, some with visible nucleoli, and variable cytoplasm. The sample has a pink and purple color palette.

Ovarian cancer generally presents as non-specific abdominal symptoms such as abdominal discomfort and swelling. It may also be associated with urinary frequency or post menopausal bleeding. More advanced disease may present with loss of appetite or weight loss.
Diagnosis should be reached by clinical examination of the abdominal mass, followed by investigations to include full blood count, chest x-ray, pelvic ultrasound and an abdominal/pelvic CT scan together with measurement of serum levels of CA-125 (a marker for ovarian cancer).
If ovarian cancer is diagnosed early the chance of being cured is normally good. Treatment for ovarian cancer depends on the staging. If the tumour is confined to one ovary, surgery alone may be sufficient. If the tumour is more advanced, chemotherapy may also be indicated.
Ovarian cancer misdiagnosis
To succeed in a medical negligence claim you need to prove that the delay affected the outcome. Usually this means you need to prove that during the delay the cancer progressed to a more advanced stage. Therefore, delays of a few months are unlikely to be enough. However if cancer is left, it is likely to grow and can spread to other parts of the body. Mistakes in diagnosing ovarian cancer can therefore be very serious. Ovarian cancer misdiagnosis claims may be brought for:
- Failure to carry out adequate examination or take an accurate history
- Failure to refer a patient to a gynaecological oncologist for further investigation
- Mistakes in interpreting the investigations (full blood count, chest x-ray, pelvic ultrasound and an abdominal/pelvic CT scan or serum levels of CA-125)
- Mistaken diagnosis of ovarian cancer often resulting in unnecessary surgery
Our award-winning team believes in putting clients first. We are dedicated to achieving the best results possible and pride ourselves on our sensitive approach. Any of our ovarian cancer misdiagnosis claims solicitors below will be pleased to discuss your case and offer free advice over the phone.

Types of Cancer Compensation Claims










